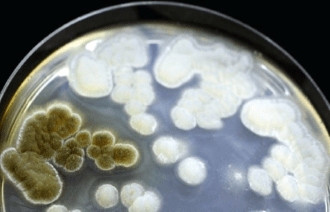

The Mysterious Deadly New Fungus: Emergomyces africanus
It is not often that completely novel pathogens are identified, but in 2013 this is exactly what happened in South Africa. Continue reading The Mysterious Deadly New Fungus: Emergomyces africanus
